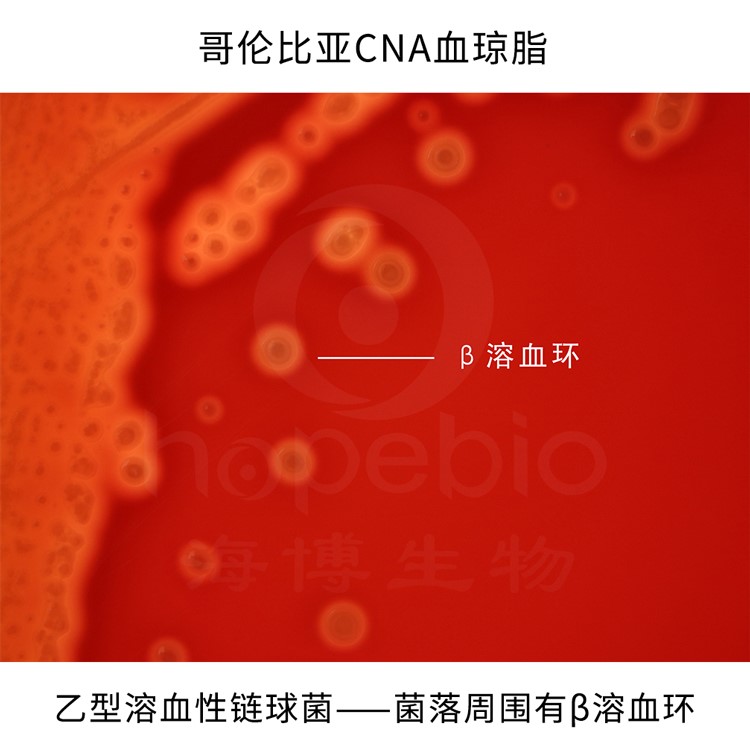

海博微信公众号
海博微信公众号
 海博天猫旗舰店
海博天猫旗舰店


 海博微信公众号
海博微信公众号
 海博天猫旗舰店
海博天猫旗舰店




在养殖业发展过程中,养殖场环境中的有害菌是威胁养殖动物健康、阻碍行业稳定发展的重要因素。这些有害菌潜藏在空气、土壤、饲料、饮水等多个环节,不仅会导致养殖动物患病,还可能间接危害人类健康,因此深入了解其种类、影响并采取科学防治措施至关重要。
一、养殖场环境中常见的有害菌类别
养殖场环境复杂,有害菌种类多样,根据其传播路径和主要侵害部位,可划分为三大核心类别,每类都包含对养殖动物危害显著的典型菌株。
1、消化道有害菌
这类有害菌主要通过污染饲料和饮水进入养殖动物体内,直接破坏消化系统功能,是养殖场中最易引发群体性疾病的类别之一。常见的有致病性大肠杆菌、沙门氏菌、产气荚膜梭菌。致病性大肠杆菌在各类养殖动物中均易传播,尤其对幼龄动物威胁极大,O157:H7属于肠出血性大肠埃希氏菌(EHEC),是致病性大肠杆菌中危害最严重的类型之一,典型大肠杆菌O157:H7在O157显色培养基上的菌落特征如图1所示;沙门氏菌宿主范围广,鸡、猪、牛等均可能感染,且具有人畜共患风险,其在沙门氏菌显色培养基上的菌落形态如图2所示;产气荚膜梭菌则在高温高湿环境下易滋生,对禽类和仔猪的肠道损伤尤为严重,其在血平皿上的菌落特征如图3所示。

图1 O157显色培养基用于O157菌的显色培养。
典型大肠杆菌O157:H7菌显亮红色、淡红色或红色,菌落周围没有蓝色晕圈;大肠杆菌和大肠菌群显蓝色或紫色,菌落周围有蓝色晕圈;其它细菌显蓝色、黄色或无色。

图2 沙门氏菌显色培养基用于沙门氏菌的显色培养。
在沙门氏菌显色培养基上,沙门氏菌菌落显紫色或紫红色,变形杆菌属、志贺氏菌属等不发酵乳糖的细菌菌落呈无色、白色或灰色,能发酵乳糖的大肠菌群菌落呈蓝色或蓝绿色。

图3 产气荚膜梭菌在血平皿上的溶血现象为有双层溶血环,内环完全溶血,是由于θ毒素的作用;外环不完全溶血则是由α毒素所致。
2、呼吸道有害菌
该类有害菌多存在于养殖场空气当中,通过养殖动物的呼吸作用侵入呼吸道,引发各类呼吸道疾病,且传播速度快,易在密集养殖环境中爆发。典型代表包括多杀性巴氏杆菌、胸膜肺炎放线杆菌、支原体。多杀性巴氏杆菌可感染鸡、鸭、猪、牛等多种畜禽;胸膜肺炎放线杆菌主要针对猪群,是规模化猪场常见的致病菌;支原体则对鸡和猪的危害最为突出,易导致慢性呼吸道疾病,猪肺炎支原体菌落镜检结果如图4所示。

图4 猪肺炎支原体菌落镜检结果
3、皮肤及黏膜有害菌
此类有害菌主要通过接触传播,当养殖动物皮肤出现伤口或黏膜受损时,便会趁机侵入,引发局部乃至全身性感染。常见的有金黄色葡萄球菌、链球菌。金黄色葡萄球菌在奶牛养殖中危害尤为明显,同时也会感染猪、鸡等,其在金黄色葡萄球菌显色培养基(第二代)上的菌落特征如图5所示;链球菌则可感染多种畜禽,不仅会造成皮肤炎症,还可能侵入血液循环引发败血症,乙型溶血性链球菌在哥伦比亚CNA血琼脂上的菌落特征如图6所示。

图5 金黄色葡萄球菌显色培养基(第二代)用于金黄色葡萄球菌的显色培养。
典型的金黄色葡萄球菌为凸起的紫红色菌落。枯草芽孢杆菌为蓝绿色菌落,粪肠球菌为蓝绿色菌落。
图6 乙型溶血性链球菌在哥伦比亚CNA血琼脂上有β溶血环。
二、典型有害菌对养殖动物的具体影响
不同有害菌对养殖动物的危害侧重点不同,从生长发育到生产性能,再到生命安全,均会产生不同程度的负面影响。
1、消化道有害菌的影响
致病性大肠杆菌感染后,仔猪会出现严重的黄痢、白痢,粪便呈黄色或白色稀糊状,日均体重增长速度下降30%-50%,若未及时治疗,死亡率可达20%-40%;成年猪感染后则会出现顽固性腹泻,消化吸收功能紊乱,饲料转化率降低15%-20%。沙门氏菌感染蛋鸡后,会导致鸡群出现严重腹泻,产蛋量骤降10%-30%,蛋壳表面可能附着细菌,引发蛋品污染;感染仔猪时,仔猪会出现体温升高至40℃-41℃、精神萎靡、食欲废绝等症状,部分仔猪会因脱水和败血症死亡。产气荚膜梭菌对肉鸡的危害极大,感染后肉鸡会出现坏死性肠炎,肠道黏膜充血、坏死,粪便中夹杂血丝或黏液,死亡率可达5%-15%,存活的肉鸡生长迟缓,出栏时间延迟7天-10天。
2、呼吸道有害菌的影响
多杀性巴氏杆菌感染鸡群时,会引发禽霍乱,病鸡出现呼吸困难、张口呼吸、咳嗽等症状,体温升高至42℃-43℃,急性病例在发病1天-2天内死亡,死亡率高达50%-80%;感染猪群时,会导致猪肺疫,病猪肺部出现出血、坏死,严重影响呼吸功能,生长速度减缓,饲料利用率降低20%以上。胸膜肺炎放线杆菌感染猪群后,会引发急性出血性胸膜肺炎,病猪突然发病,口鼻流出带血泡沫,呼吸急促,短时间内(2小时-6小时)便会死亡,急性疫情下猪群死亡率可达30%-60%;慢性感染的猪则会出现间歇性咳嗽,生长发育受阻,出栏体重较健康猪降低10%-15%。支原体感染蛋鸡时,会导致鸡慢性呼吸道疾病,鸡群出现咳嗽、打喷嚏、眼部肿胀等症状,产蛋量下降5%-15%,同时蛋品合格率降低;感染仔猪时,会引发猪支原体肺炎,病猪长期咳嗽,生长缓慢。
3、皮肤及黏膜有害菌的影响
金黄色葡萄球菌感染奶牛时,会引发急性乳腺炎,奶牛乳房红肿、疼痛,乳汁中出现凝块和血丝,日产奶量下降30%-50%,严重时乳房组织坏死,奶牛失去产奶能力;感染仔猪时,会导致仔猪皮肤出现脓疱,破裂后形成溃疡,影响仔猪正常活动和进食,死亡率可达10%-20%。链球菌感染猪群时,会引发猪链球菌病,病猪体温升高至41℃-42℃,出现神经症状(如转圈、倒地不起),关节肿胀、疼痛,无法正常站立,急性病例死亡率可达40%-60%;感染鸡群时,会导致鸡出现败血症,鸡冠发紫、呼吸困难,死亡速度快,对鸡群成活率影响极大。
三、养殖场细菌防控的科学措施:从传统治理到生物革新
1、传统防控措施
(1)环境清洁与物理防控:定期清理圈舍粪便、垫料,及时清除有机污染物(有害菌的主要营养来源);保持圈舍通风透气,降低空气中细菌浓度;对养殖器械(挤奶机、阉割工具)进行高温高压灭菌,避免交叉感染。
(2)化学消毒常态化:选用过氧乙酸、氢氧化钠、季铵盐类等消毒剂,定期对圈舍地面、墙面、饮水槽、饲料槽进行喷洒消毒;针对粪便堆积区、污水池等重点区域,增加消毒频次,减少有害菌滋生。
(3)免疫接种与生物安全:针对高发有害菌(如沙门氏菌、胸膜肺炎放线杆菌、多杀性巴氏杆菌),为动物接种疫苗,提升机体特异性免疫力;严格管控人员、车辆进出,设置消毒通道,避免外部有害菌带入;对发病动物及时隔离治疗,病死动物进行无害化处理,防止疫情扩散。
(4)饲料与饮水优化:确保饲料储存干燥通风,避免霉变(霉变饲料易滋生有害菌并产生毒素);饮水系统采用过滤、紫外线消毒或加氯消毒,保证饮水卫生,减少消化道有害菌的传播途径。
2、新型生物防控
随着绿色养殖理念的普及,传统化学防控的局限性日益凸显,噬菌体制剂作为“细菌的天敌”,以其特异性强、无残留、无耐药性等优势,成为养殖场环境改良的新型利器,尤其适用于环境喷洒防控。
(1)噬菌体制剂的防控原理:噬菌体是一类专门侵染细菌的病毒,具有高度的宿主特异性-仅能识别并裂解特定的有害菌(如针对大肠杆菌的噬菌体只作用于大肠杆菌,不伤害枯草芽孢杆菌、乳酸菌等有益菌)。将噬菌体制剂喷洒在养殖场环境中,噬菌体可主动寻找并侵入有害菌体内,利用有害菌的代谢系统复制自身,最终裂解细菌,使有害菌浓度显著降低;同时,噬菌体在裂解细菌后会释放出新的子代噬菌体,继续侵染环境中的有害菌,形成“链式裂解反应”,实现对有害菌的持续控制。
(2)噬菌体制剂的应用优势:与传统化学消毒剂相比,噬菌体制剂具有三大核心优势:一是环保无残留,噬菌体在完成裂解任务后会自然降解,不会在环境中积累,也不会污染土壤、水源;二是不产生耐药性,噬菌体通过物理侵染方式裂解细菌,细菌难以对其产生抗性,有效解决了抗生素和化学消毒剂引发的耐药性问题;三是保护有益菌,其特异性作用机制可精准靶向有害菌,不破坏环境中的有益菌群落,有助于维持养殖场微生态平衡,从根源上改善养殖环境。
(3)噬菌体制剂的应用场景与方法:噬菌体制剂可广泛应用于养殖场的多个场景:一是圈舍环境喷洒,按一定浓度稀释后,对地面、墙面、垫料进行均匀喷洒,尤其适用于仔猪舍、雏鸡舍等幼龄动物饲养区域,降低腹泻、呼吸道疾病风险;二是粪便与污水处理,向粪便堆积区、污水池喷洒制剂,加速有害菌裂解,减少氨气、硫化氢等异味气体产生,降低环境污染;三是饮水与饲料添加,将噬菌体制剂加入饮水或混合在饲料中,直接作用于动物肠道内的有害菌,协同改善体内外微生态环境。应用时需注意,根据养殖场高发有害菌类型,选择针对性的噬菌体制剂(如针对猪舍大肠杆菌的制剂、鸡舍支原体的制剂),并按照说明书控制使用浓度和频次,确保防控效果。
本公司有培养和鉴定以上菌种的相关培养基,表1仅展示部分相关培养基,详情请见青岛海博生物官网青岛海博生物-快速显色微生物培养基生产-植物组织培养基制造(hopebiol.com)。
表1 青岛海博生物相关产品信息
|
产品编号 |
产品名称 |
规格 |
产品说明及用途 |
|
GS005 |
20支/盒 |
用于大肠埃希氏菌O157菌、沙门氏菌和志贺氏菌生化鉴定 |
|
|
GB004 |
20支/盒 |
用于大肠杆菌生化鉴定 |
|
|
GS006 |
20支/盒 |
用于大肠埃希氏菌O157菌、沙门氏菌和志贺氏菌、霍乱弧菌生化鉴定 |
|
|
GB007 |
20支 |
用于蜡样、沙门、志贺氏菌的生化鉴定 |
|
|
HB7001 |
1000ml |
用于大肠杆菌的显色快速培养 |
|
|
HB7003-7 |
1000ml |
用于快速、准确同时检测大肠杆菌和大肠菌群,培养24小时,大肠杆菌显蓝色-紫色,大肠菌群显红色 |
|
|
HB7006 |
1000ml |
用于O157菌的显色培养,O157菌显亮红色、淡红色或红色 |
|
|
HB7009-5 |
1000ml |
用于金黄色葡萄球菌的显色培养,金黄色葡萄球菌显紫红色 |
|
|
HBPM7007-1 |
9cm*10个/包 |
用于沙门氏菌的显色培养,沙门氏菌显紫色 |
注:本文属海博生物原创,未经允许不得转载。
| 相关文章: | ||



